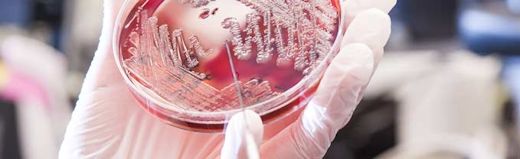
bacteriology banner

Bacteriology and Mycology
Disease Specific Specimen Selection and Collection
The Microbiology laboratory of the KVDL provides high quality diagnostic bacteriology and mycology services to practicing veterinarians, the Veterinary Health Center, researchers and industry. This is an AAVLD accredited laboratory.
Services Include
- Culture for isolation and identification of Aerobic and anaerobic and fungal pathogens
- Antimicrobial susceptibility testing for pathogens of veterinary significance
- ELISA-based detection of Clostridium difficile toxins
- Culture-based detection of Mycoplasma spp.
If you do not find a specific test listed, please contact Client Services at (785) 532-5650, toll free at 1-866-512-5650 or clientcare@vet.k-state.edu for special testing submission and fees.